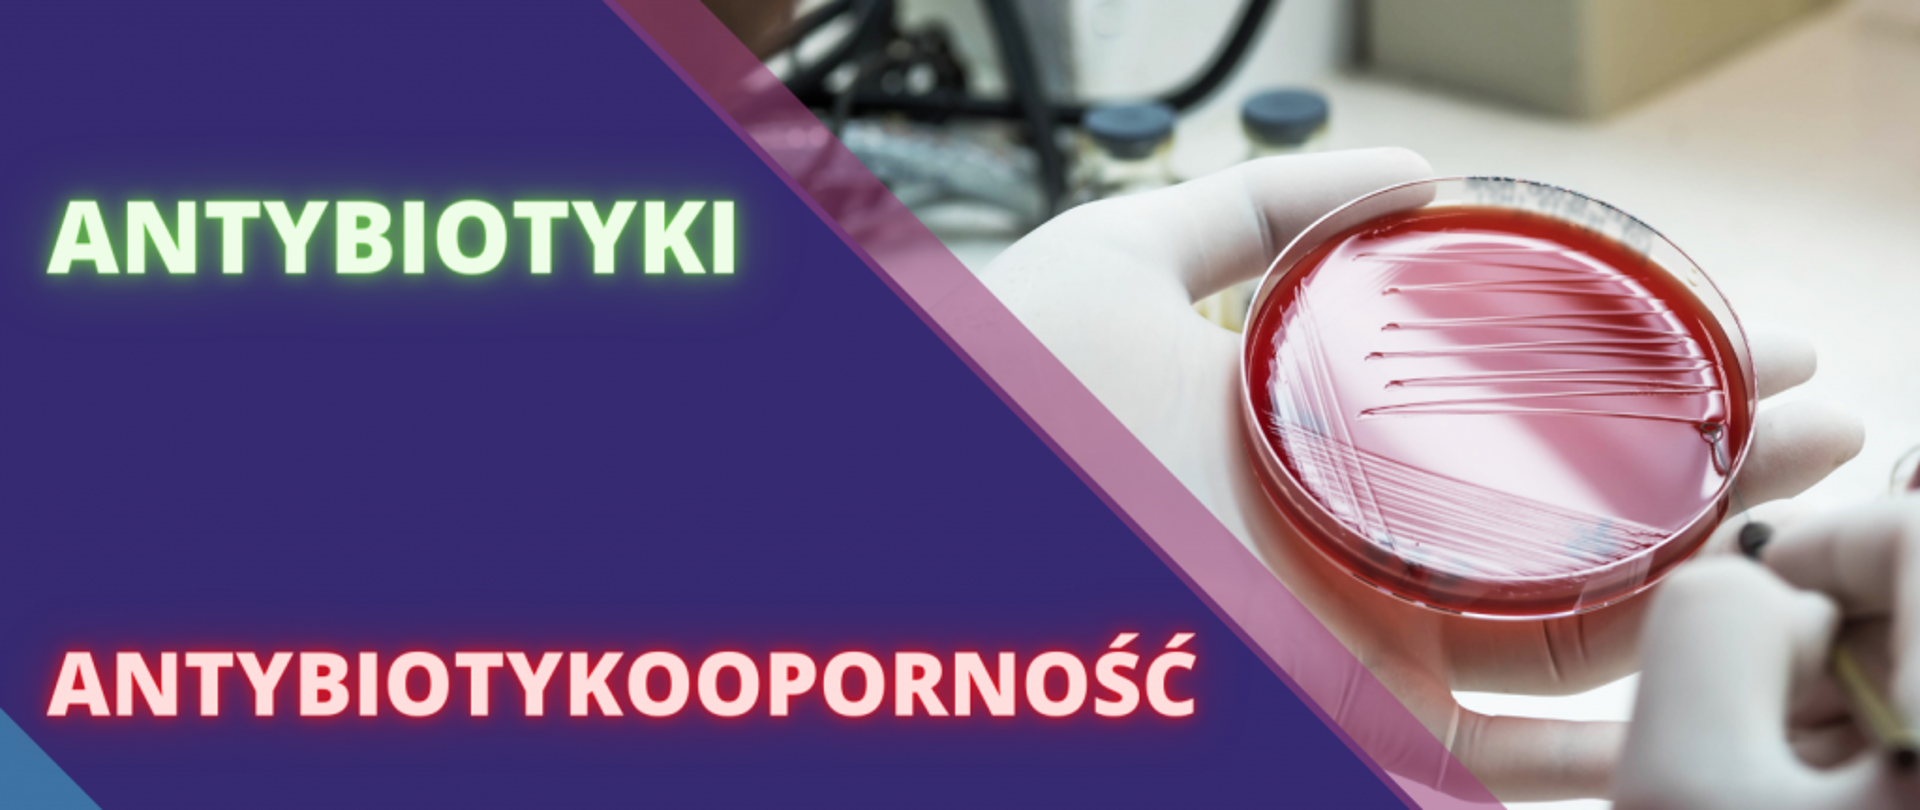
Antybiotykooporność oraz 75. rocznica powstania WHO

Antybiotykooporność oraz 75. rocznica powstania WHO
05.04.2023
W latach 2000-2015 globalne stosowanie antybiotyków wzrosło o 65%. Światowa Organizacja Zdrowia (WHO) szacuje, że oporność mikroorganizmów na leki przyczynia się rocznie do 75 tys. zgonów.
Nawet co piąty antybiotyk przepisywany jest niepotrzebnie, przez co maleje ich skuteczność w walce z naprawdę groźnymi infekcjami. Z powodu antybiotykooporności liczba zgonów na świecie do roku 2050 może wzrosnąć nawet do 10 milionów rocznie.
Główne przyczyny antybiotykooporności to:
- nadmierne lub niepotrzebne stosowanie antybiotyków
- nieprzestrzeganie zaleceń lekarza dotyczących dawkowania
- przerywanie antybiotykoterapii po ustąpieniu objawów infekcji
- nadużywanie antybiotyków podczas produkcji żywności
- nieprzestrzeganie zasad higieny.
Materiały
Ulotka: Antybiotykooporność oraz 75. rocznica powstania WHOUlotka- Antybiotykooporność oraz 75. rocznica powstania WHO.pdf 0.74MB